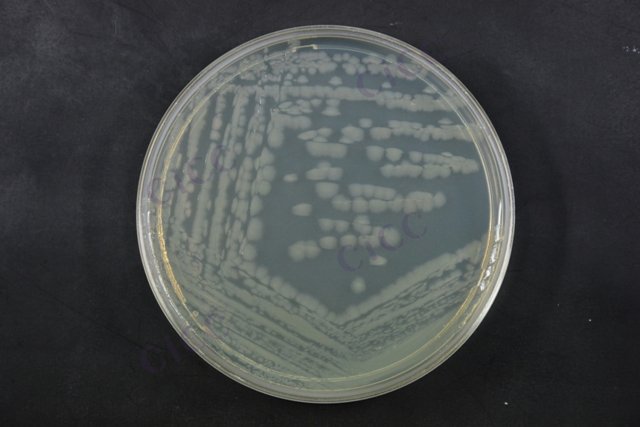
铜绿假单胞菌 Pseudomonas aeruginosa CICC 21636 Pseudomonas aeruginosa

铜绿假单胞菌 Pseudomonas aeruginosa CICC 21636 Pseudomonas aeruginosa
-
铜绿假单胞菌 Pseudomonas aeruginosa CICC 21630 Pseudomonas aeruginosa
CICC 21630 | 见证书
-
铜绿假单胞菌 Pseudomonas aeruginosa CICC 10204 Pseudomonas aeruginosa
CICC 10204 | 见证书
-
铜绿假单胞菌 Pseudomonas aeruginosa CICC 10205 Pseudomonas aeruginosa
CICC 10205 | 见证书
-
铜绿假单胞菌 Pseudomonas aeruginosa CICC 10299 Pseudomonas aeruginosa
CICC 10299 | 见证书
-
铜绿假单胞菌 Pseudomonas aeruginosa CICC 10351 Pseudomonas aeruginosa
CICC 10351 | 见证书
-
铜绿假单胞菌 Pseudomonas aeruginosa CICC 10419 Pseudomonas aeruginosa
CICC 10419 | 见证书
-
铜绿假单胞菌 Pseudomonas aeruginosa CICC 24649 Pseudomonas aeruginosa
CICC 24649 | 见证书

说明书下载: 菌种说明书 打管说明书
您正在浏览的产品:铜绿假单胞菌 Pseudomonas aeruginosa CICC 21636
手机版:铜绿假单胞菌 Pseudomonas aeruginosa CICC 21636
本公司销售的所有产品仅供实验科研使用,不用于人体及临床诊断。
适用于饮用天然矿泉水中铜绿假单胞菌的检验,通过滤膜法检测250 mL水样中的微生物[1]。
使用0.45 μm滤膜截留微生物,CN琼脂培养基36℃培养24~48小时,结合菌落颜色、荧光特性及乙酰胺肉汤、氧化酶试验进行确认[1][8]。
限量规定为n=5,c=0,m=0 CFU/250mL(即5份样品中均不得检出)[1][5]。
需确保无菌操作环境,使用已验证的CN琼脂培养基,定期进行培养基性能测试[1][8]。
①水样过滤;②滤膜转移至CN琼脂;③36℃培养观察;④绿脓菌素和乙酰胺试验确认[1][8]。
紫外线检查菌落时需避免长时间照射,防止杀灭目标菌;需区分产绿脓素与非产绿脓素菌株[1][8]。
针对化妆品中铜绿假单胞菌的检测,需结合产品微生物风险分析(如水分活度、pH值)确定适用性[2]。
使用增菌肉汤预培养,再接种至选择性琼脂培养基,通过生化试剂盒或分子方法鉴定[2][3]。
依据产品类型调整检测灵敏度,高风险产品需达到≤10 CFU/g的定量限[2]。
需包含阳性对照菌株(如ATCC 9027),验证培养基选择性和试剂有效性[2][3]。
①样品均质化处理;②增菌培养24小时;③选择性分离培养;④氧化酶试验和API鉴定[2][3]。
不适用于与水不混溶的油性产品,此类样品需参照ISO 18415进行改良方法验证[2][3]。
以上信息仅供参考,请以相应标准的原文为准!